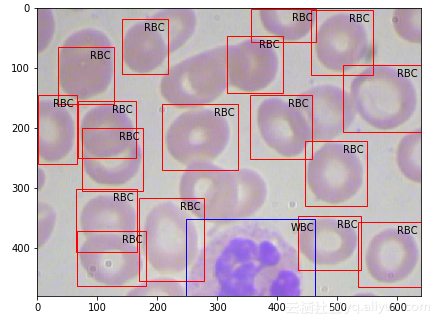
4 4
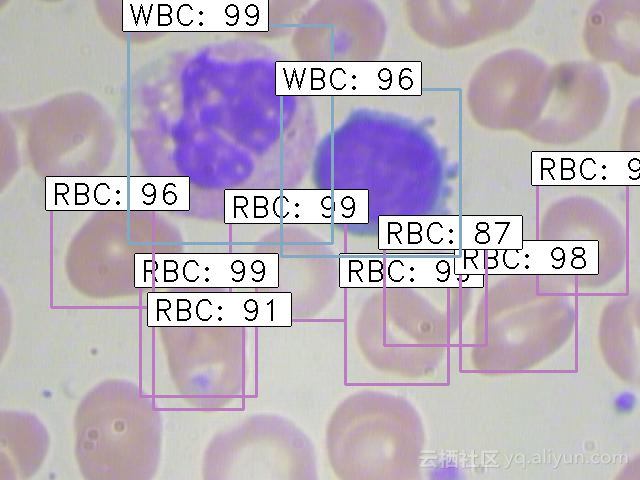
5 5
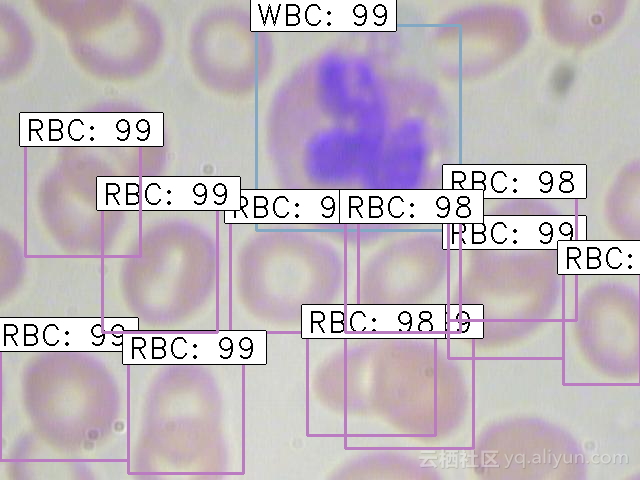
6 6
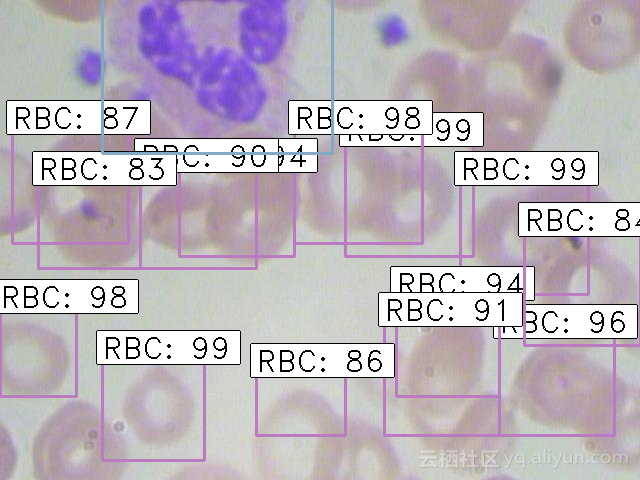
7 7
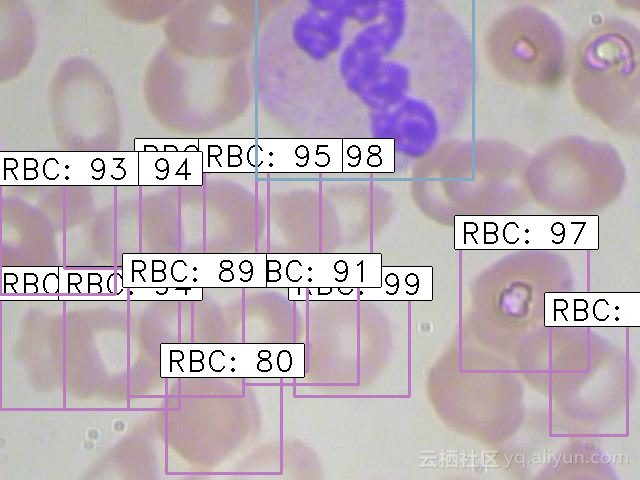
8 8

目标检测一直是计算机视觉中比较热门的研究领域,有一些常用且成熟的算法得到业内公认水平,比如RCNN系列算法、SSD以及YOLO等。如果你是从事这一行业的话,你会使用哪种算法进行目标检测任务呢?在我寻求在最短的时间内构建最精确的模型时,我尝试了其中的R-CNN系列算法,如果读者们对这方面的算法还不太了解的话,建议阅读《目标检测算法图解:一文看懂RCNN系列算法》。在掌握基本原理后,下面进入实战部分。
本文将使用一个非常酷且有用的数据集来实现faster R-CNN,这些数据集具有潜在的真实应用场景。

问题陈述
数据来源于医疗相关数据集,目的是解决血细胞检测问题。任务是通过显微图像读数来检测每张图像中的所有红细胞(RBC)、白细胞(WBC)以及血小板。最终预测效果应如下所示:

选择该数据集的原因是我们血液中RBC、WBC和血小板的密度提供了大量关于免疫系统和血红蛋白的信息,这些信息可以帮助我们初步地识别一个人是否健康,如果在其血液中发现了任何差异,我们就可以迅速采取行动来进行下一步的诊断。
通过显微镜手动查看样品是一个繁琐的过程,这也是深度学习模式能够发挥重要作用的地方,一些算法可以从显微图像中分类和检测血细胞,并且达到很高的精确度。
本文采用的血细胞检测数据集可以从 这里下载,本文稍微修改了一些数据:
- 边界框已从给定的.xml格式转换为.csv格式;
- 随机划分数据集,得到训练集和测试集;
这里使用流行的Keras框架构建本文模型。
系统设置
在真正进入模型构建阶段之前,需要确保系统已安装正确的库和相应的框架。运行此项目需要以下库:
- pandas
- matplotlib
- tensorflow
- keras – 2.0.3
- numpy
- opencv-python
- sklearn
- h5py
对于已经安装了Anaconda和Jupyter的电脑而言,上述这些库大多数已经安装好了。建议从此链接下载requirements.txt文件,并使用它来安装剩余的库。在终端中键入以下命令来执行此操作:
pip install -r requirement.txt
系统设置好后,下一步是进行数据处理。
数据探索
首先探索所拥有的数据总是一个好开始(坦率地说,这是一个强制性的步骤)。对数据熟悉有助于挖掘隐藏的模式,还可以获得对整体的洞察力。本文从整个数据集中创建了三个文件,分别是:
-
train_images:用于训练模型的图像,包含每个图像的类别和实际边界框; -
test_images:用于模型预测的图像,该集合缺少对应的标签; -
train.csv:包含每个图像的名称、类别和边界框坐标。一张图像可以有多行数据,因为单张图像可能包含多个对象;
读取.csv文件并打印出前几行:
# importing required libraries
import pandas as pd
import matplotlib.pyplot as plt
%matplotlib inline
from matplotlib import patches
# read the csv file using read_csv function of pandas
train = pd.read_csv(‘train.csv’)
train.head()

训练文件中总共有6列,其中每列代表的内容如下:
-
image_names:图像的名称; -
cell_type:表示单元的类型; -
xmin:图像左下角的x坐标; -
xmax:图像右上角的x坐标; -
ymin:图像左下角的y坐标; -
ymax:图像右上角的y坐标;
下面打印出一张图片来展示正在处理的图像:
# reading single image using imread function of matplotlib
image = plt.imread('images/1.jpg')
plt.imshow(image)
上图就是血细胞图像的样子,其中,蓝色部分代表WBC,略带红色的部分代表RBC。下面看看整个训练集中总共有多少张图像和不同类型的数量。
# Number of classes
train['cell_type'].value_counts()
结果显示训练集有254张图像。
# Number of classes
train['cell_type'].value_counts()
结果显示有三种不同类型的细胞,即RBC,WBC和血小板。最后,看一下检测到的对象的图像是怎样的:
fig = plt.figure()
#add axes to the image
ax = fig.add_axes([0,0,1,1])
# read and plot the image
image = plt.imread('images/1.jpg')
plt.imshow(image)
# iterating over the image for different objects
for _,row in train[train.image_names == "1.jpg"].iterrows():
xmin = row.xmin
xmax = row.xmax
ymin = row.ymin
ymax = row.ymax
width = xmax - xmin
height = ymax - ymin
# assign different color to different classes of objects
if row.cell_type == 'RBC':
edgecolor = 'r'
ax.annotate('RBC', xy=(xmax-40,ymin+20))
elif row.cell_type == 'WBC':
edgecolor = 'b'
ax.annotate('WBC', xy=(xmax-40,ymin+20))
elif row.cell_type == 'Platelets':
edgecolor = 'g'
ax.annotate('Platelets', xy=(xmax-40,ymin+20))
# add bounding boxes to the image
rect = patches.Rectangle((xmin,ymin), width, height, edgecolor = edgecolor, facecolor = 'none')
ax.add_patch(rect)
上图就是训练样本示例,从中可以看到,细胞有不同的类及其相应的边界框。下面进行模型训练,本文使用
keras_frcnn库来训练搭建的模型以及对测试图像进行预测。
faster R-CNN实现
为了实现 faster R-CNN算法,本文遵循此Github存储库中提到的步骤。因此,首先请确保克隆好此存储库。打开一个新的终端窗口并键入以下内容以执行此操作:
git clone https://github.com/kbardool/keras-frcnn.git
并将train_images和test_images文件夹以及train.csv文件移动到该存储库目录下。为了在新数据集上训练模型,输入的格式应为:
filepath,x1,y1,x2,y2,class_name
其中:
- filepath是训练图像的路径;
- x1是边界框的xmin坐标;
- y1是边界框的ymin坐标;
- x2是边界框的xmax坐标;
- y2是边界框的ymax坐标;
- class_name是该边界框中类的名称;
这里需要将.csv格式转换为.txt文件,该文件具有与上述相同的格式。创建一个新的数据帧,按照格式将所有值填入该数据帧,然后将其另存为.txt文件。
data = pd.DataFrame()
data['format'] = train['image_names']
# as the images are in train_images folder, add train_images before the image name
for i in range(data.shape[0]):
data['format'][i] = 'train_images/' + data['format'][i]
# add xmin, ymin, xmax, ymax and class as per the format required
for i in range(data.shape[0]):
data['format'][i] = data['format'][i] + ',' + str(train['xmin'][i]) + ',' + str(train['ymin'][i]) + ',' + str(train['xmax'][i]) + ',' + str(train['ymax'][i]) + ',' + train['cell_type'][i]
data.to_csv('annotate.txt', header=None, index=None, sep=' ')
下一步进行模型训练,使用train_frcnn.py文件来训练模型。
cd keras-frcnn
python train_frcnn.py -o simple -p annotate.txt
由于数据集较大,需要一段时间来训练模型。如果条件满足的话,可以使用GPU来加快训练过程。同样也可以尝试减少num_epochs参数来加快训练过程。
模型每训练好一次(有改进时),该特定时刻的权重将保存在与“model_frcnn.hdf5”相同的目录中。当对测试集进行预测时,将使用到这些权重。
根据机器的配置,可能需要花费大量时间来训练模型并获得权重。建议使用本文训练大约500个时期的权重作为初始化。可以从这里下载这些权重,并设置好相应的路径。
因此,当模型训练好并保存好权重后,下面进行预测。Keras_frcnn对新图像进行预测并将其保存在新文件夹中,这里只需在test_frcnn.py文件中进行两处更改即可保存图像:
-
从该文件的最后一行删除注释:
- cv2.imwrite('./ results_imgs / {}。png'.format(idx),img);
-
在此文件的倒数第二行和第三行添加注释:
- #cv2.imshow('img',img) ;
- #cv2.waitKey(0);
使用下面的代码进行图像预测:
python test_frcnn.py -p test_images
最后,检测到对象的图像将保存在“results_imgs”文件夹中。以下是本文实现faster R-CNN后预测几个样本获得的结果:
结果1
结果2
结果3
结果4
总结
R-CNN算法确实是用于对象检测任务的变革者,改变了传统的做法,并开创了深度学习算法。近年来,计算机视觉应用的数量突然出现飙升,而R-CNN系列算法仍然是其中大多数应用的核心。
Keras_frcnn也被证明是一个很好的对象检测工具库,在本系列的下一篇文章中,将专注于更先进的技术,如YOLO,SSD等。
作者信息
PULKIT SHARMA,机器学习和深度学习
本文由阿里云云栖社区组织翻译。
文章原标题《A Practical Implementation of the Faster R-CNN Algorithm for Object Detection (Part 2 – with Python codes)》,译者:海棠,审校:Uncle_LLD。
文章为简译,更为详细的内容,请查看原文。
本文详细介绍使用Faster R-CNN算法进行血细胞检测的全过程,包括数据预处理、模型训练及预测。通过实例展示了算法在医疗领域的应用潜力。
2066

被折叠的 条评论
为什么被折叠?



